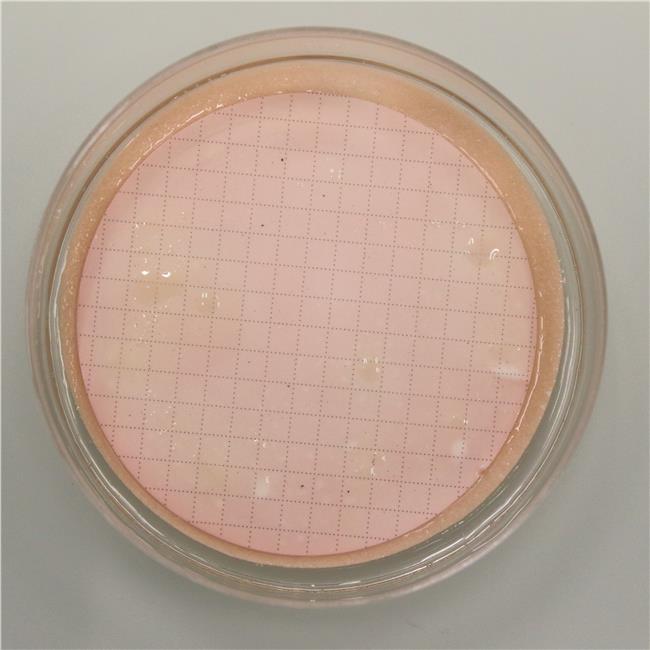

Easy DryTM are absorbent pads saturated with a sterile, dehydrated culture medium. Each pad is pre-plated in a Petri dish and is immediately ready to use after pouring sterile distilled or deionized water on it. Easy DryTM are optimal for the examination of large sample volumes by the membrane filter method.
Easy DryTM MacConkey is a slightly selective medium giving excellent differentiation between lactose- fermenting and lactose-nonfermenting Gram-negative enteric bacilli, from foodstuffs, waste water, pharmaceutical, and industrial sources.
This medium conforms to harmonized USP/EP/JP requirements for the detection of E. coli in nonsterile pharmaceutical products.
PREPARATION
1.
Cut open a bag and remove the number of Easy Dry plates needed.
2.
Moisten the pad contained
in the Petri dish with 2.2 ml of sterile distilled or deionized water.
3.
Wait 5 minutes before
using.
TEST PROCEDURE
Filter the sample through a filter membrane (0.45 µm pore diameter). Transfer the membrane onto a plate containing a just rehydrated pad. Incubate aerobically at 30-35°C for 18-72 h.
INTERPRETING RESULTS
Lactose-nonfermenting organisms, such as Salmonella, Shigella and Proteus spp, form colorless or clear colonies. Lactose-fermenting organisms, such as E. coli and Klebsiella spp, grow as pink to red colonies with or without a zone of precipitated bile. Enterococci, Staphylococci and other Gram-positive bacteria are partially or completely inhibited.
To confirm the presence of E. coli, transfer the membrane and the colonies onto a pad of Easy DryTM TBX (ref. 87503), just rehydrated and pre-warmed to 44°C, for the detection of ß-glucuronidase activity. More than 94 % of E. coli strains are ß-glucuronidase-positive and will grow as blue to blue-green colonies on TBX Agar. Typical reactions for detection of E. coli are a positive indole-reaction as well as a negative oxidase- and catalase- reaction.
APPEARANCE OF THE MEDIUM
Pinkish pad. Slightly darker once rehydrated.
STORAGE
Store at 10-25°C away from light. Do not
use the product beyond its expiry date on the label or if product shows any
evidence of contamination or any sign of deterioration.
SHELF LIFE
2 years.